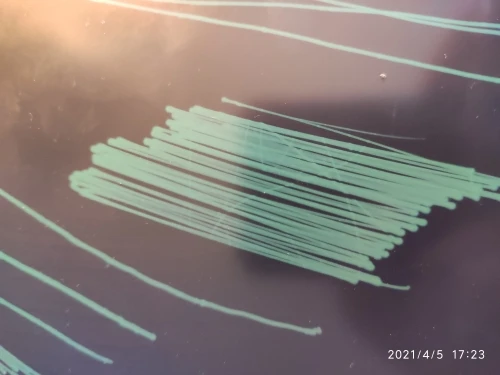

2022 New 20" Xiaomi Mijia LCD Writing Tablet with Pen 10/13.5" Digital Drawing Electronic Handwriting Pad Message Graphics Board
10.49
–
28.99
$
9
orders
/
1
reviews
Price history
- for 3 month
- for half a year
- Requires Alitools extension
The Alitools extension is required to keep track of an item and receive notifications when prices drop.
Price drop notification
9.97 $ (-5%)
9.97 $ (-5%)
9.44 $ (-10%)
8.92 $ (-15%)
8.39 $ (-20%)
Out telegram bot will notify you once the price drops to the desirable one
This item is from other sellers
Similar Products
Customer Reviews
R***n
December 9, 2020
Should have been better packaged - product is ok - but the plastic around it - inside box was broken ALOT - so cant be used as a gift product is very nice
R***n
December 9, 2020
Should have been better packaged - product is ok - but the plastic around it - inside box was broken ALOT - so cant be used as a gift product is very nice
Anonymous